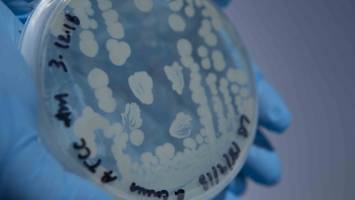
New food poisoning toxin

news
Australian National University
Results 281 - 300 of 669.
Health - Life Sciences - 05.05.2020
Gene research could lead to cancer breakthrough
New research by scientists at The Australian National University (ANU) will help us better understand rare forms of cancer.
Environment - 30.04.2020
Shows you are what you eat when it comes to survival
A new study of human teeth from islands in Southeast Asia shows how our earliest ancestors' diets set them up for survival in harsh, new environments, allowing them to thrive while other species died off. The research team, including archaeologists from The Australian National University (ANU) studied a collection of human teeth found on the islands of Timor and Alor - part of the region known as Wallacea.
Economics - Administration - 21.04.2020

New international research has found that cutting corners on workplace safety to boost short-term financial gains may be rife among companies burdened with debt. The researchers anticipate the problem will only worsen as the COVID-19 crisis smashes the world's economies. Dr Di Fan from The Australian National University (ANU), who co-led the research, warned that Australian companies were susceptible to having a "myopic focus" at workers' expense.
Astronomy & Space - 06.04.2020
Far stars firmly in sight thanks to telescope teamwork
Stars far, far away could appear a lot closer when viewed through our telescopes thanks to new research from The Australian National University (ANU). The research has also brought the properties of nearby stars into never before seen precision, and could allow us to catch a rare glimpse of the conditions of planets orbiting them in the future.
Environment - Life Sciences - 13.03.2020
Birds are the "canaries in the climate-change coal mine"
A bird study led by The Australian National University (ANU) provides new understanding of the ways birds and mammals respond to a rapidly warming world. The researchers say the findings offer insights into the pressures wild populations must manage in order to survive. The future survival of animal populations will depend on how they are able to respond to climate change.
Environment - 09.03.2020
Indian Ocean phenomenon spells climate trouble for Australia
New international research has found a worrying change in the Indian Ocean's surface temperatures that puts southeast Australia on course for increasingly hot and dry conditions. The work led by The Australian National University (ANU) and the ARC Centre of Excellence for Climate Extremes has a silver lining, helping to improve our understanding of climate variations and the management of risk caused by Indian Ocean variability.
Health - 20.02.2020
Scientists at The Australian National University (ANU) have discovered new details about the tools used by bacteria to trigger dangerous food poisoning symptoms. They've shown for the first time how a new toxin can infect our cells, even when the body has successfully fought off others. Food poisoning is estimated to affect more than 4.1 million Australians every year - costing the economy $1.25 billion, and in some cases can cause death.
Environment - 17.02.2020

The environment has rocketed up to either number one or two on the list of worries for about half of Australian voters, according to a new poll from The Australian National University (ANU). The January 2020 ANUpoll also found the greatest drop in support for new coal mines was among Australian adults who voted for the Coalition at last year's Federal Election - from 72 per cent support in June 2019 to 57 per cent in January 2020.
Environment - 17.02.2020

The environment has rocketed up to either number one or two on the list of worries for about half of Australian voters, according to a new poll from The Australian National University (ANU). The January 2020 ANUpoll also found the greatest drop in support for new coal mines was among Australian adults who voted for the Coalition at last year's Federal Election - from 72 per cent support in June 2019 to 57 per cent in January 2020.
Social Sciences - 17.02.2020

More than three quarters of Australian adults report that they were affected by the nation's recent unprecedented bushfires, according to a new poll from The Australian National University (ANU). The latest ANUpoll also found the Government's response to the bushfires had burnt away at Prime Minister Scott Morrison's approval rating and popularity with voters.
Astronomy & Space - 24.01.2020

Astronomers have found a 'vampire' star in the midst of a feeding frenzy, with the help of an automated program that is sifting through archived data from the decommissioned Kepler Space Telescope. The new program acts like a detective to find clues of very fast, mysterious explosions in the Universe.
Life Sciences - 15.01.2020

As Australia's weather heats up, it could have serious consequences for some of our country's most iconic animals, according to new research from The Australian National University (ANU). The research shows marsupials like koalas, possums and gliders are forced to change their eating habits in hot weather because of the toxins found in Eucalyptus leaves.
Astronomy & Space - 06.01.2020
The curious case of a star crash in a galaxy far, far away
The detection of two neutron stars colliding in space about five billion trillion kilometres away has left an international team of scientists scratching their heads.
Social Sciences - 19.12.2019
Caring for mates not number of beers is responsible drinking
As the Christmas party season gears up, new research from The ANU has found Australians don't know, and 'wildly underestimate' guidelines for responsible drinking. Despite this, Australians felt a deep sense of social responsibility to others when drinking and uniformly cited drink driving as the ultimate act of irresponsible drinking.
Health - 18.12.2019
Scheme to change energy use hurts vulnerable households
Potential pricing policies to support integration of renewable energy sources into electricity grids could leave the most vulnerable households facing greater financial burdens, new research has found. According to the study, charging more for energy usage during 'on-peak' times could disproportionately impact the health and finances of already vulnerable households.
Physics - Astronomy & Space - 12.12.2019
A quantum leap that’s been decades in the making
Science enthusiasts and the general public have become accustomed to finding out about cataclysmic events in space such as black holes colliding, as though spotting them was as easy as riding a bike. In fact, scientists only detected ripples from such an event for the first time about four years ago.
Pharmacology - 09.12.2019
Pill testing trial backed by independent review
A "trailblazing" trial run in the Australian Capital Territory, making pill testing available to festival goers, has been endorsed by an independent evaluation report from The Australian National University. The researchers say the trial worked, and could provide a model for how similar services are rolled out across the country.
Environment - 07.12.2019
Trust in government hits all time low
Trust in government has reached its lowest level on record, with just one-in-four Australians saying they had confidence in their political leaders and institutions, according to a major study of the 2019 Federal Election. The latest Australian Election Study, conducted by The Australian National University (ANU), also found Australians' satisfaction with democracy is at its lowest since the constitutional crisis of the 1970s.
Earth Sciences - Environment - 04.12.2019
Australia at its most stripped back
New research from The Australian National University (ANU) and Geoscience Australia could provide a much clearer picture of the Australian landscape, and how to better manage it under a changing climate. The study, published , shows the Australian continent at its 'barest' - or least vegetated. Dr Dale Roberts designed a new mathematical algorithm that accurately estimates the earth's reflected light at every location from satellite imagery.
Environment - 03.12.2019
Calls to curb infant formula’s carbon footprint
Urgent action is needed to protect breastfeeding and reduce formula's carbon footprint - especially for "unnecessary" toddler milks, according to an expert at The Australian National University (ANU). Dr Julie Smith, who has studied the economics of infant feeding for over 20 years, has published a paper in the International Breastfeeding Journal on the global environmental damage of milk formula, particularly greenhouse gas emissions.
Computer Science - Mar 20
New computer chip material inspired by the human brain could slash AI energy use
New computer chip material inspired by the human brain could slash AI energy use

Politics - Mar 20
Argentina 50 years on from start of dictatorship - is it forgetting the disappeared?
Argentina 50 years on from start of dictatorship - is it forgetting the disappeared?
Life Sciences - Mar 20
Courting the Competition: Some Male Fruit Flies Serenade Each Other Rather Than Fight
Courting the Competition: Some Male Fruit Flies Serenade Each Other Rather Than Fight

Social Sciences - Mar 20
Louis Theroux's manosphere documentary shows some of the subtle ways we can undermine online misogyny
Louis Theroux's manosphere documentary shows some of the subtle ways we can undermine online misogyny

Life Sciences - Mar 20
Hidden Helpers: Pittsburgh's Industrial Past Might Hold the Key to a Cleaner Future
Hidden Helpers: Pittsburgh's Industrial Past Might Hold the Key to a Cleaner Future
Pharmacology - Mar 19
GSK, University of Oxford and Imperial College London launch centre to create computer models of lungs, liver, kidneys and cartilage
GSK, University of Oxford and Imperial College London launch centre to create computer models of lungs, liver, kidneys and cartilage

Innovation - Mar 19
India's new wave of Hindu Religious Entrepreneurship is reshaping our interpretation of success
India's new wave of Hindu Religious Entrepreneurship is reshaping our interpretation of success
Pharmacology - Mar 19
Oxford University spinout Dark Blue Therapeutics acquired to advance leukaemia treatment
Oxford University spinout Dark Blue Therapeutics acquired to advance leukaemia treatment
Veterinary - Mar 19
New RVC study challenges common beliefs on desirable behaviours in designer 'Doodle' crossbreeds
New RVC study challenges common beliefs on desirable behaviours in designer 'Doodle' crossbreeds

Agronomy & Food Science - Mar 19
Bird Flu Risk to Danish Cattle - New Tool Can Warn Farmers Before Infection Spreads
Bird Flu Risk to Danish Cattle - New Tool Can Warn Farmers Before Infection Spreads









